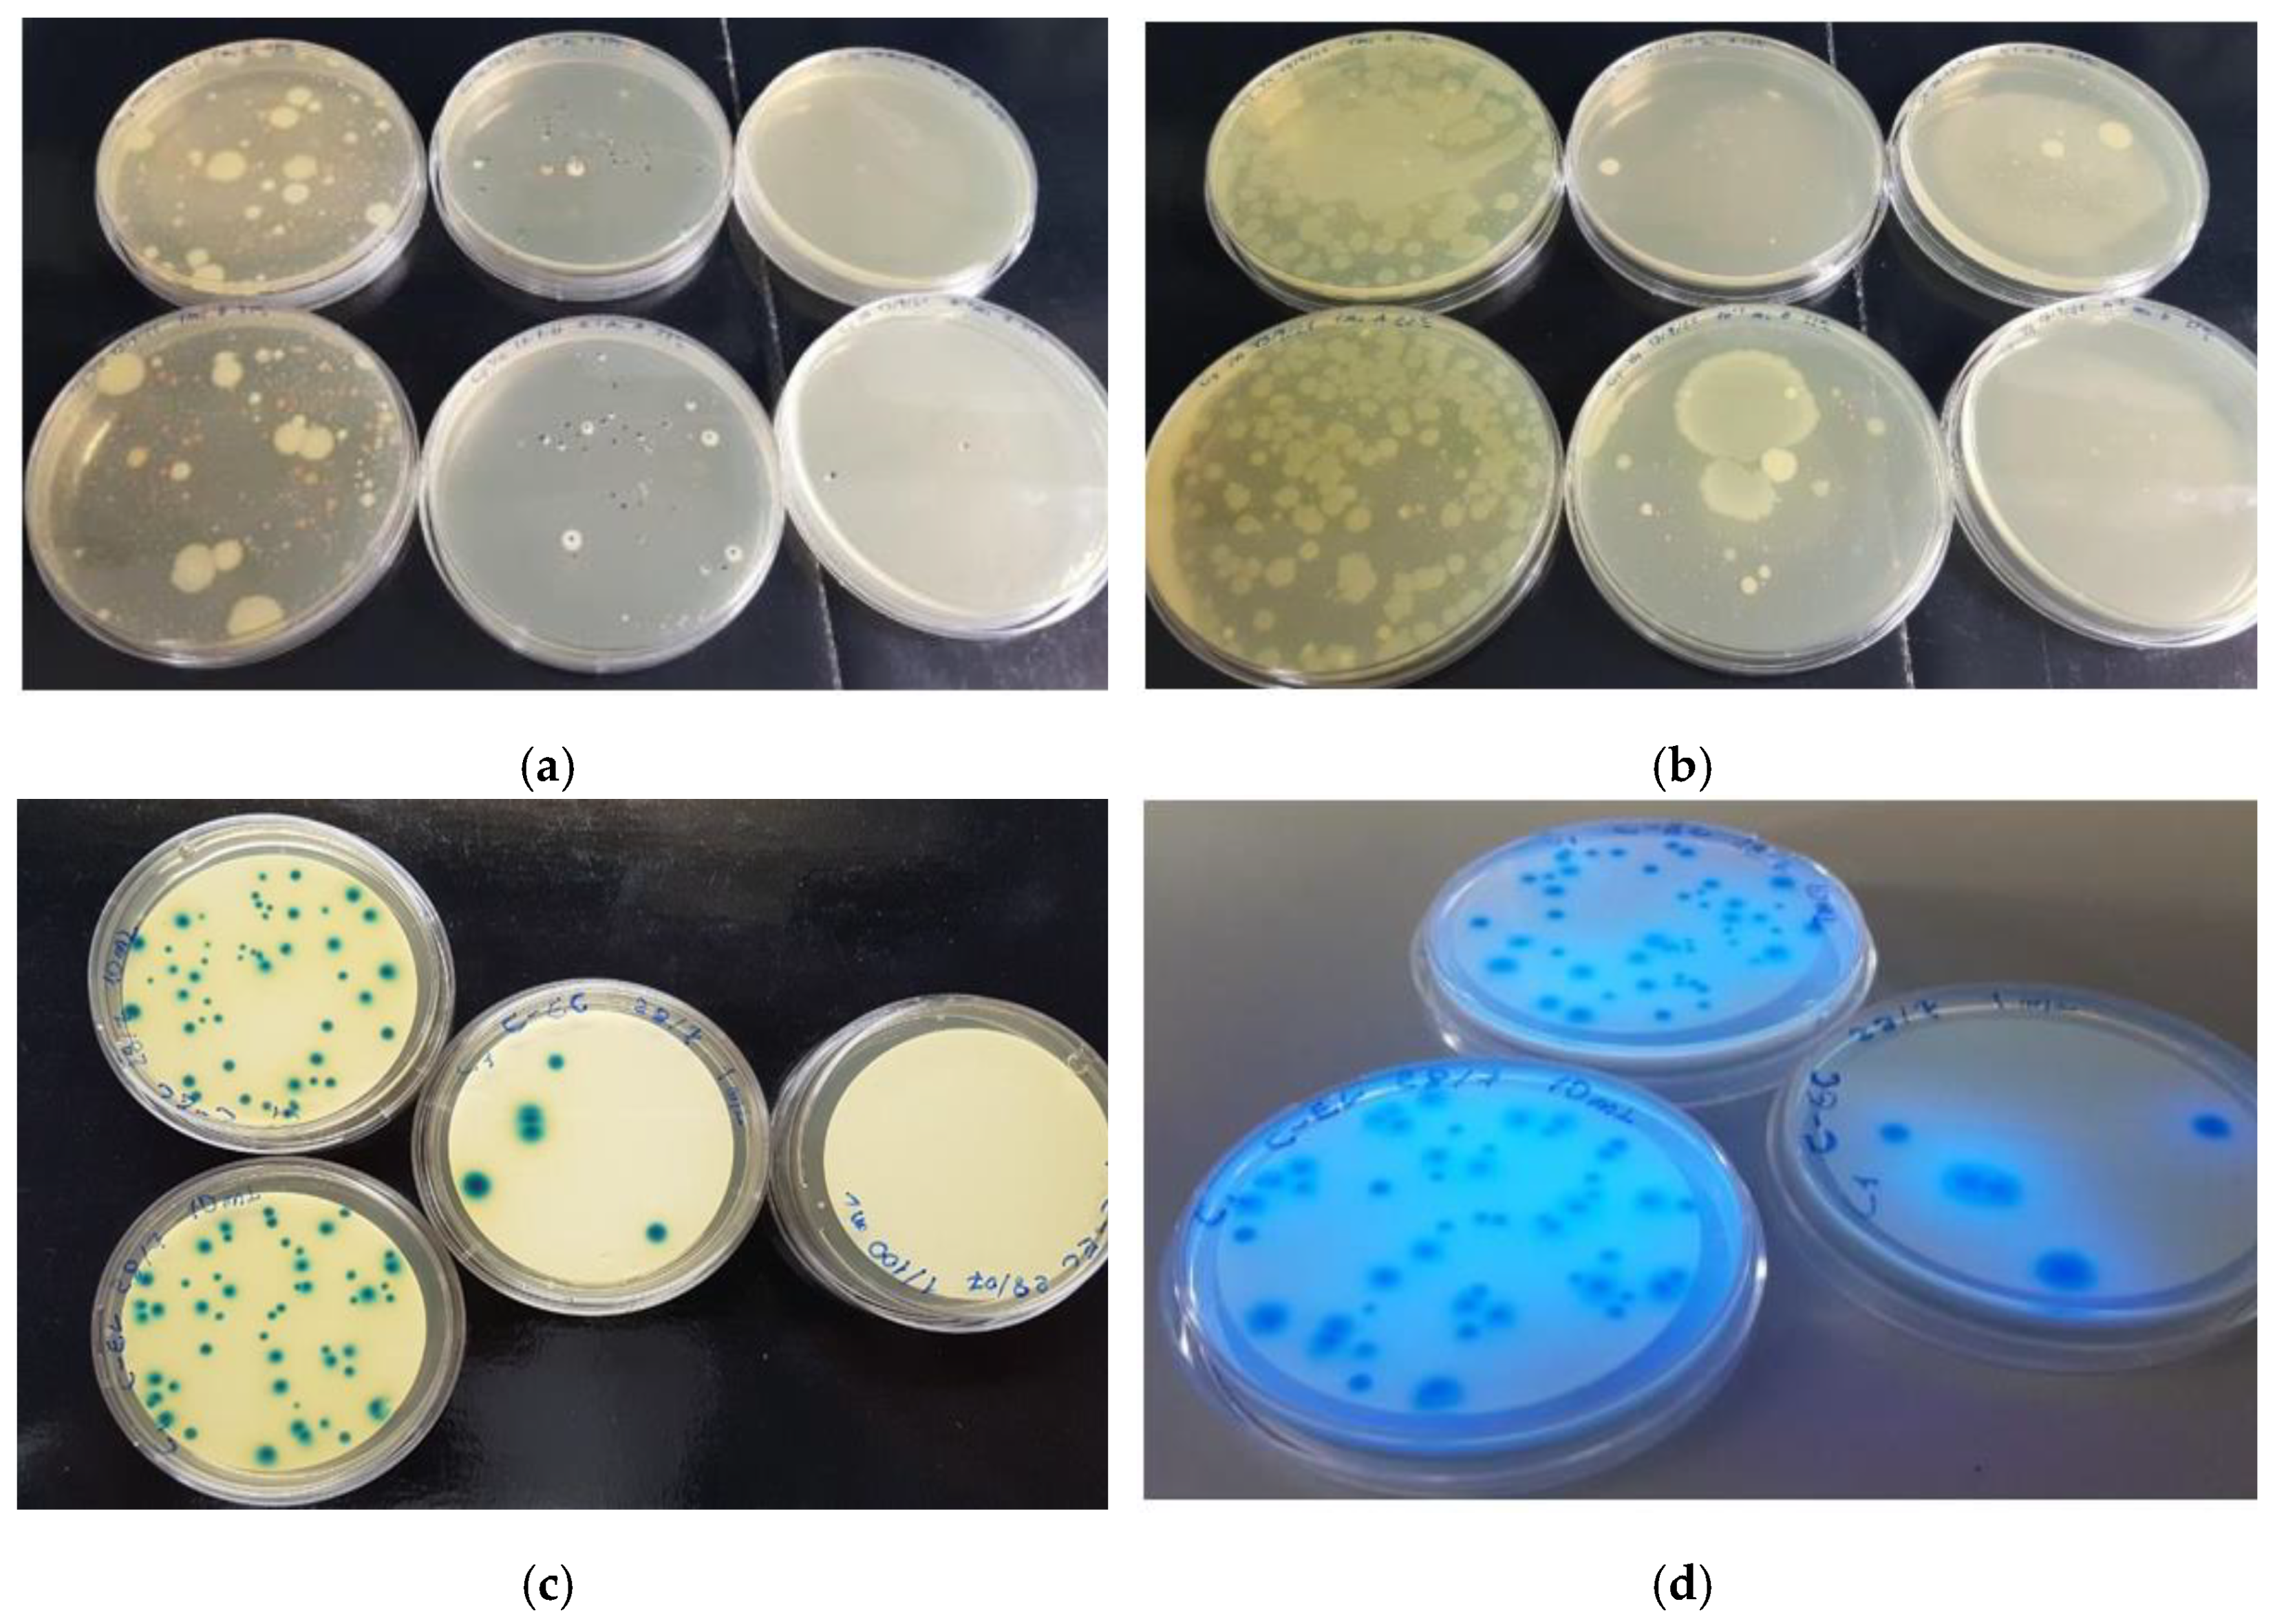
Molecules 27 08177 g004
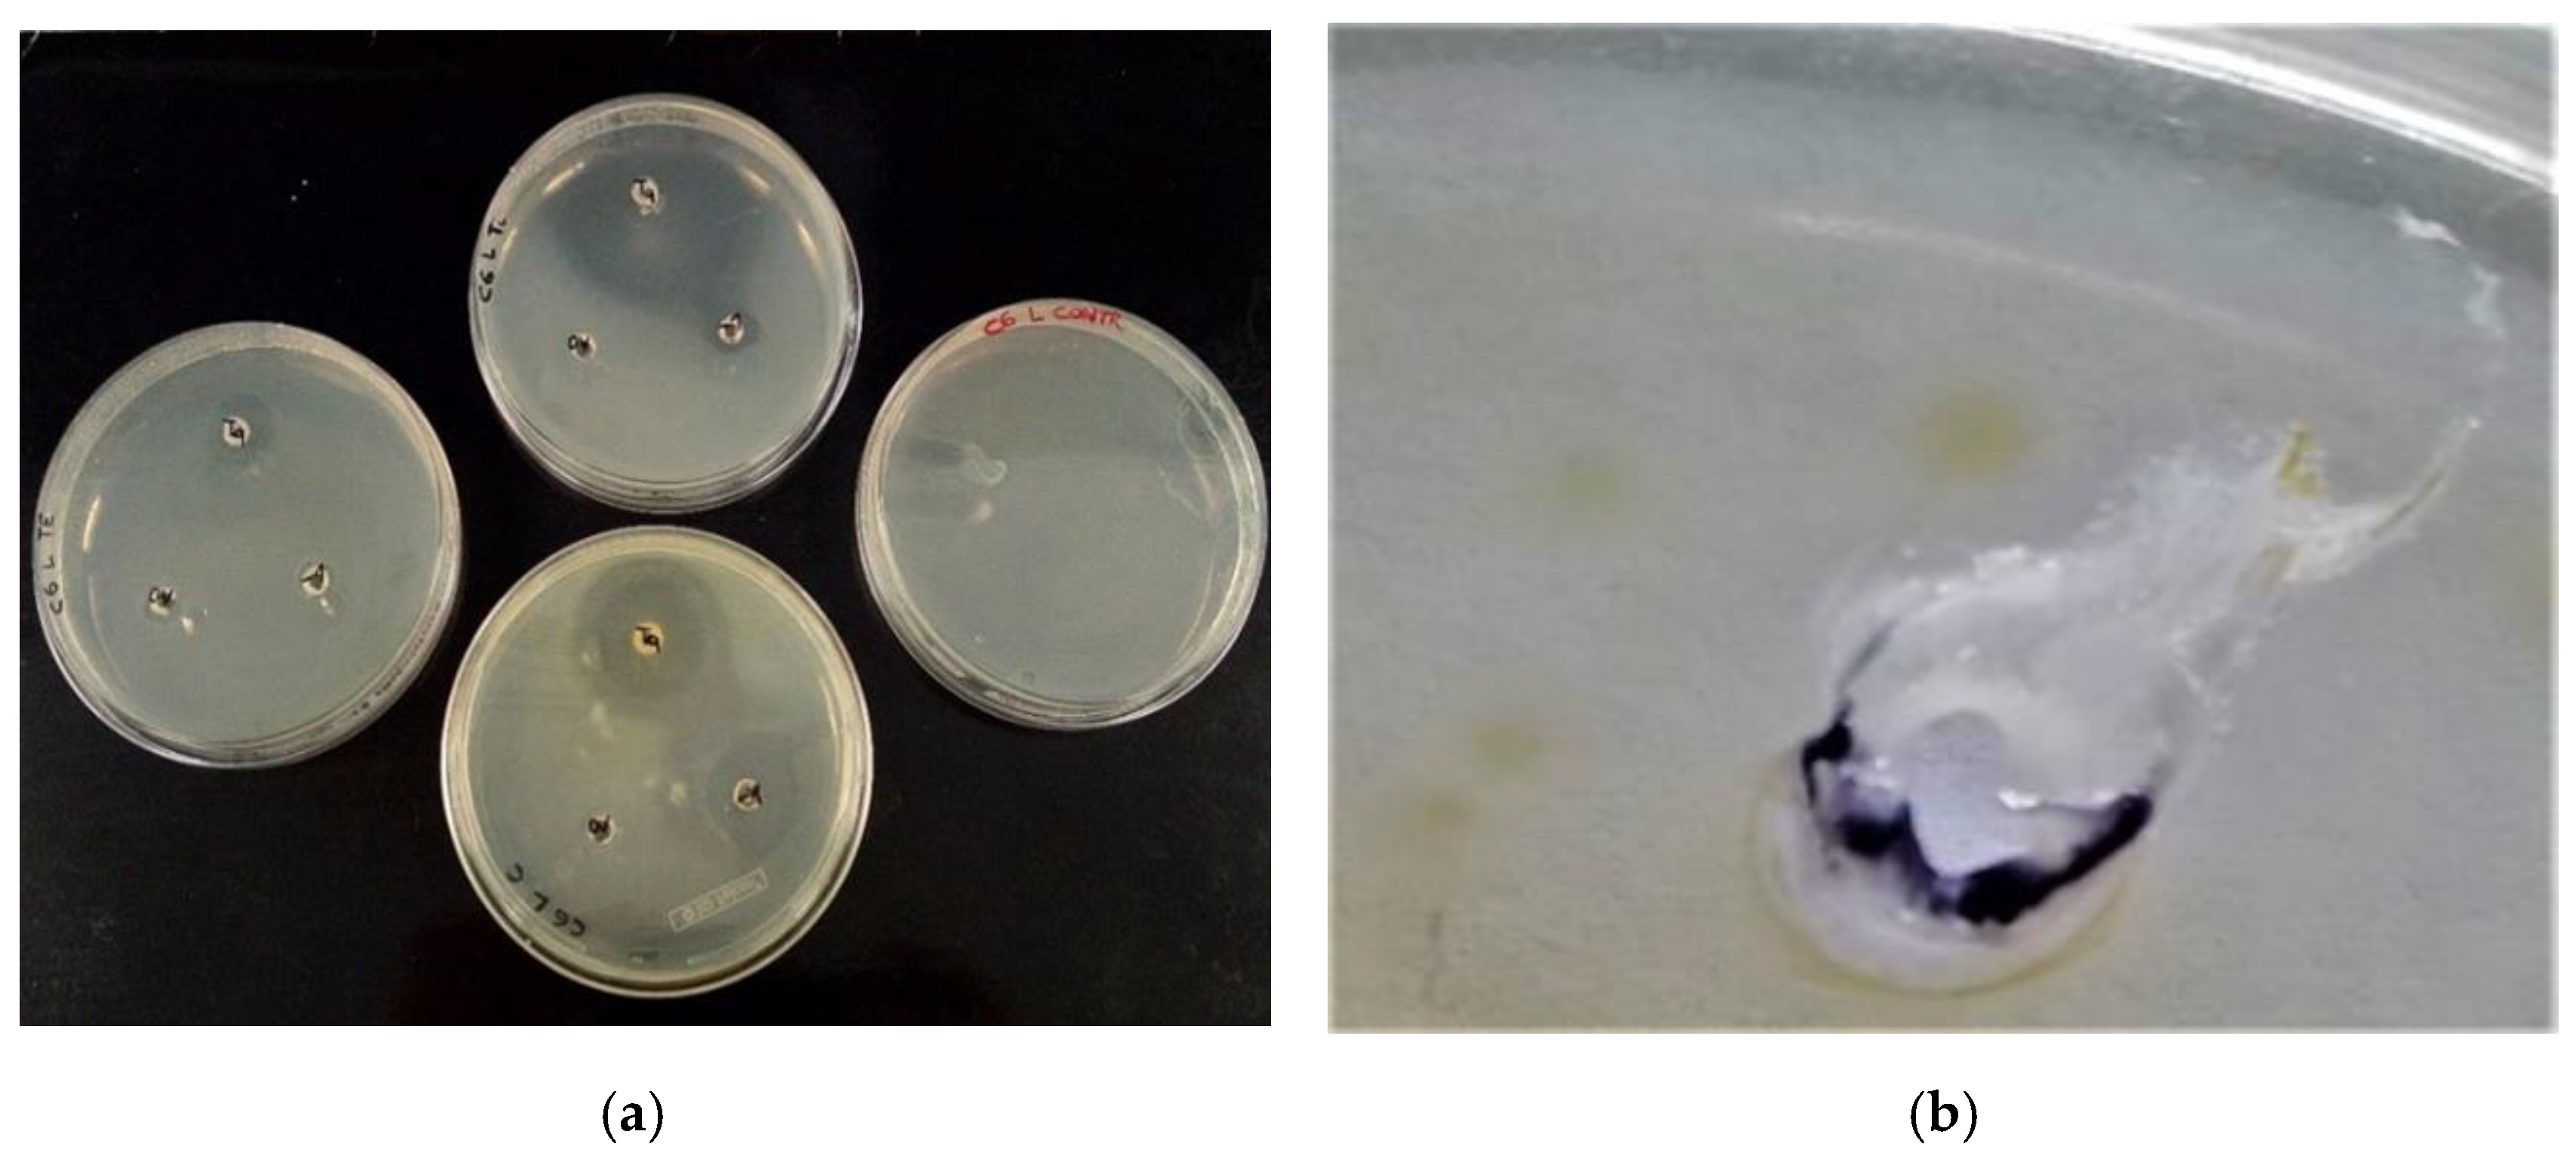
Molecules 27 08177 g007a
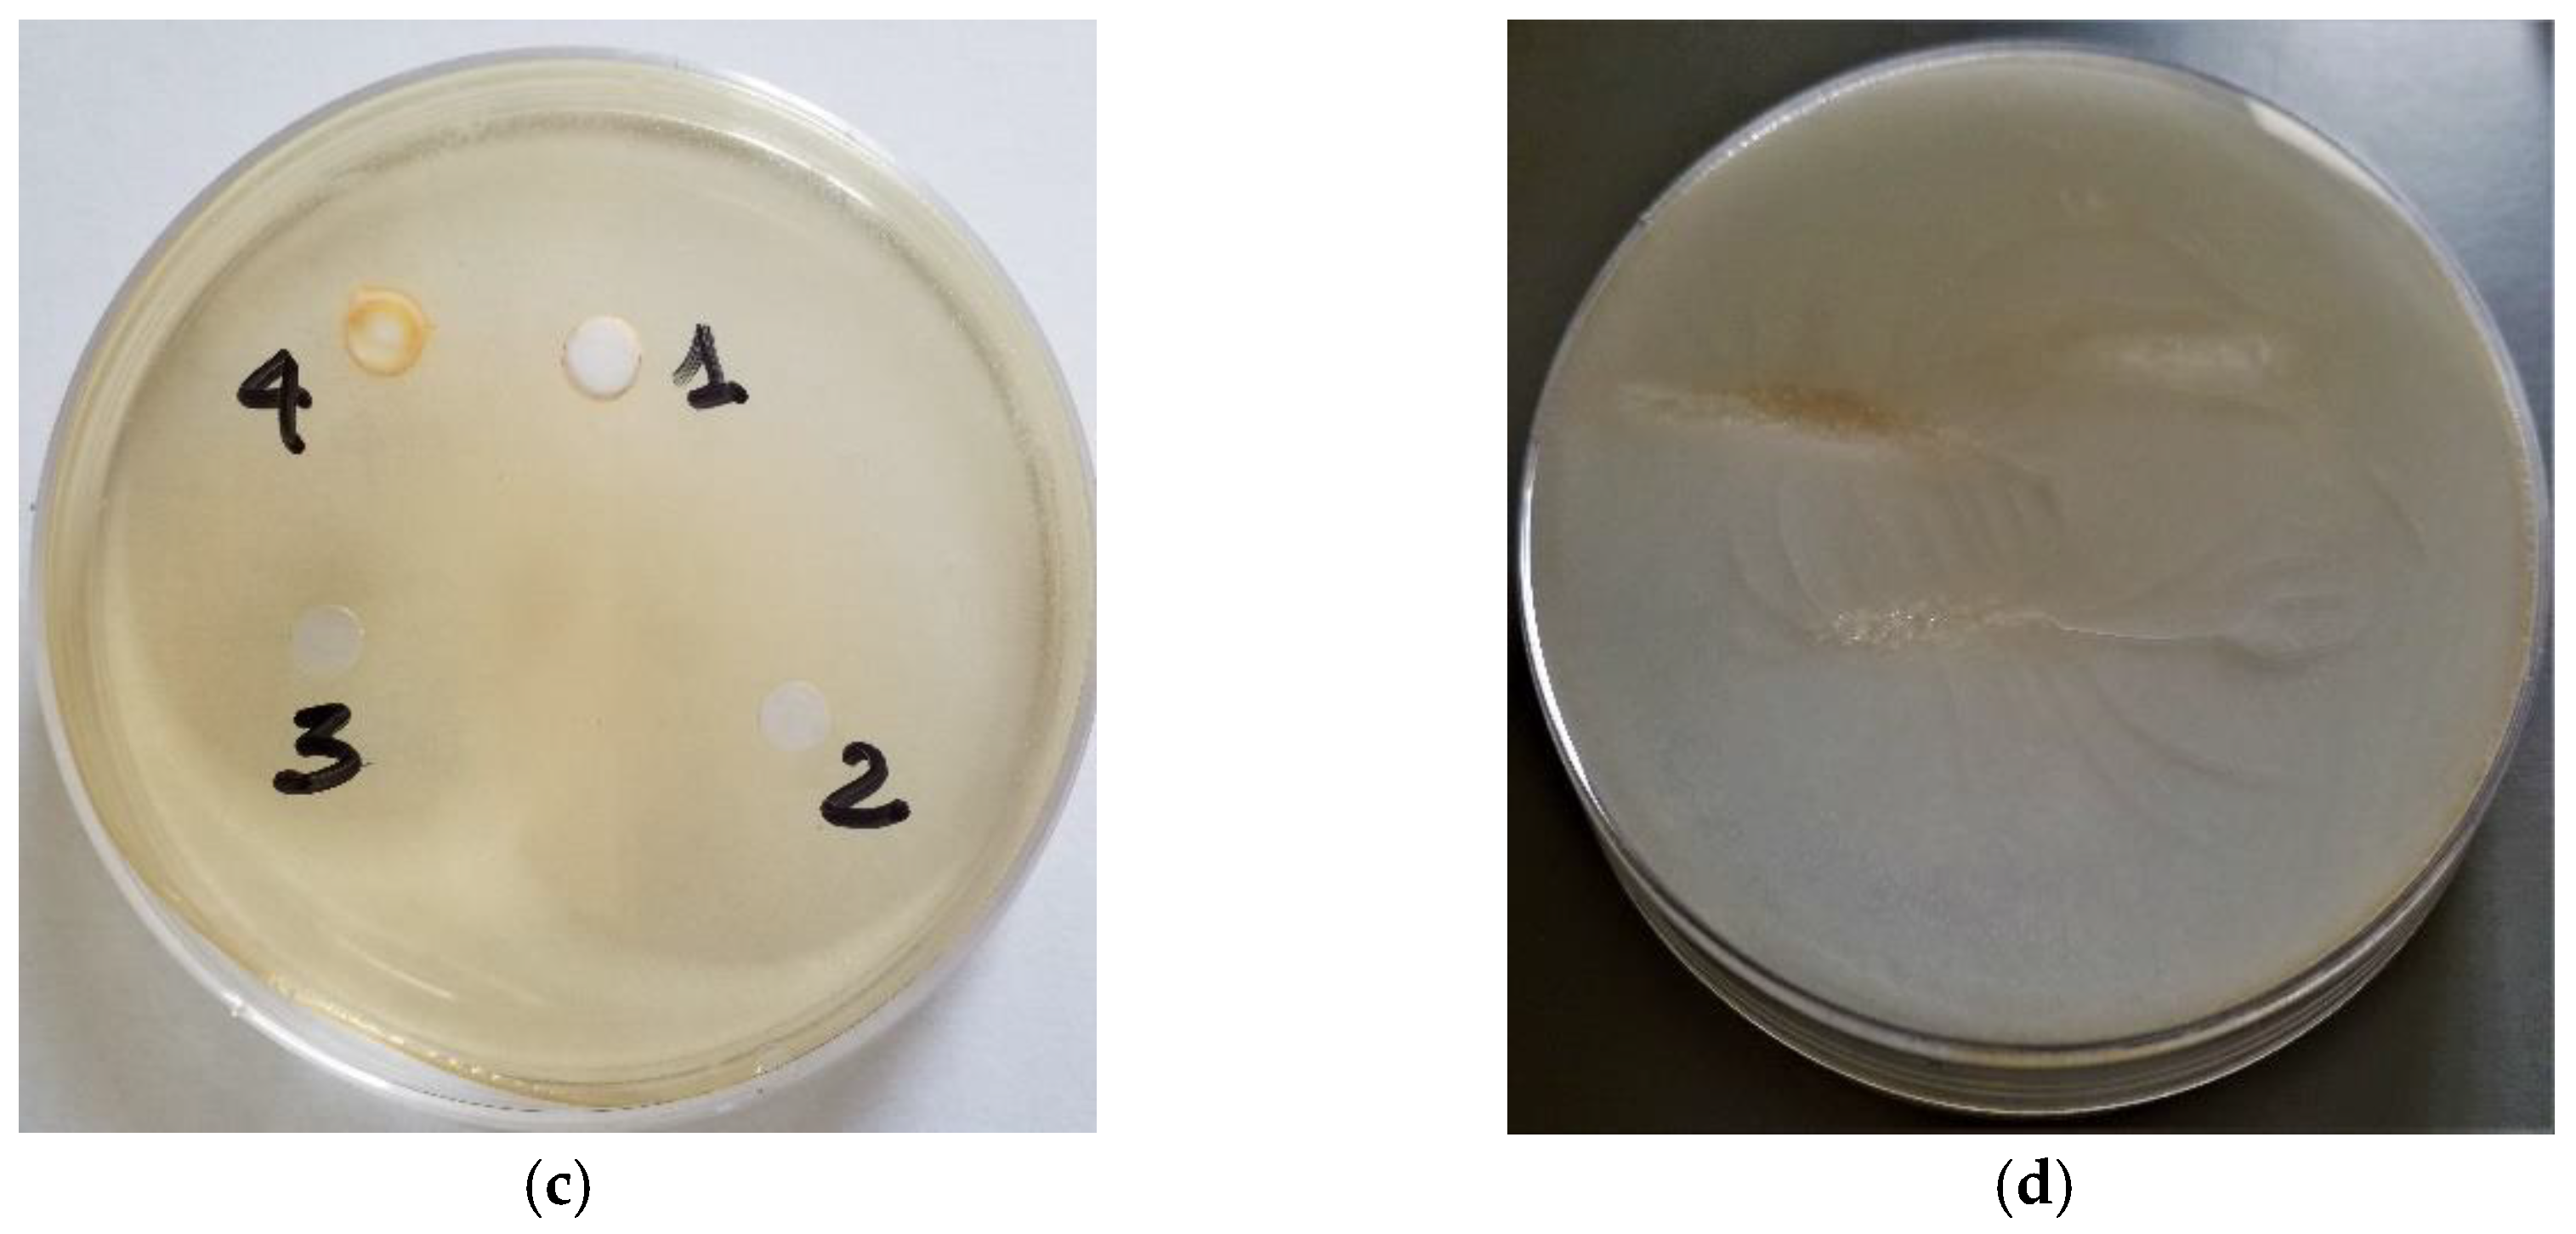
Molecules 27 08177 g007b

Effects of EOs vs. Antibiotics on E. coli Strains Isolated from Drinking Waters of Grazing Animals in the Upper Molise Region, Italy
Abstract
1. Introduction
2. Results
2.1. Chemical Composition of Selected Commercial Oils
2.2. Water Sampling Points
2.3. Environmental Data of Sites Sampled
2.4. Microbial Count in Water Pools and Stone Drinking Troughs
2.5. Antibacterial Activity against Selected E. coli
2.6. Antibacterial Activity of EOs against Selected E. coli
3. Discussion
4. Materials and Methods
4.1. Essential Oils
4.2. GC-FID Analysis
4.3. GC/MS Analysis
4.4. Identification of Essential Oil Components
4.5. Sampling and Culture Media
4.6. Antibiotics and Antibiogram
4.7. Aromatogram
4.8. Statistical Analysis
4.9. Environmental Parameters of Sites Sampled
5. Conclusions
- (i)
- provision should be made for the establishment of watering points that are safer and that can be controlled from a health point of view;
- (ii)
- the municipalities should provide for the positioning of stone drinking troughs supplied with water from the municipal water pipes;
- (iii)
- in order to assess the effects of climate change (presence/absence of rain, temporal distribution, variations in ambient water temperature, UV exposure, leaching of salts from the soil to the watering hole, metal content, dilution/concentration of viable microorganisms, survival dynamics, variations in microbial communities, etc.), it is advisable to carry out further studies over a longer time span (i.e., 5–8 years) on the quality of drinking water for free-range animals.
Supplementary Materials
Author Contributions
Funding
Institutional Review Board Statement
Informed Consent Statement
Data Availability Statement
Acknowledgments
Conflicts of Interest
Sample Availability
References
- Bindi, L. Transhumance Is the New Black. In Grazing Communities; Berghahn Books: Oxford, UK; New York, NY, USA, 2022; pp. 149–173. [Google Scholar]
- UNESCO Intergovernmental Committee Transhumance. The Seasonal Droving of Livestock along Migratory Routes in the Mediterranean and in the Alps. Available online: https://ich.unesco.org/en/decisions/14.COM/10.B.2 (accessed on 28 July 2021).
- Bonsembiante, M. Monti e Boschi; Gruppo giornalistico edagricole, S.r.l.: Milano, Italy, 1964; pp. 13–21. [Google Scholar]
- Corti, M. Produrre latte e formaggi in alpeggio: Dilemmi tecnici e visioni sociali. Caseus 2003, 6, 36–43. [Google Scholar]
- Corti, M. L’ Organizzazione dell’Alpeggio Nella Storia. Available online: http://www.ruralpini.it/Alpeggi_StoriaN.htm (accessed on 3 August 2021).
- Giovannini, G. La Pozza naturalistica. In Pozze, Abbeveratoi, Canali: Tradizioni e usi del Trentino; Provincia Autonoma di Trento-Servizio Foreste e fauna: Trento, Italy, 2015; pp. 24–33. [Google Scholar]
- Giovannini, G. Gli abbeveratoi di legno. In Pozze, Abbeveratoi, Canali: Tradizioni e usi del Trentino; Provincia Autonoma di Trento-Servizio Foreste e fauna: Trento, Italy, 2015; pp. 51–55. [Google Scholar]
- Giovannini, P. Gli abbeveratoi di pietra. In Pozze, Abbeveratoi, Canali: Tradizioni e usi del Trentino; Provincia Autonoma di Trento-Servizio Foreste e fauna: Trento, Italy, 2015; pp. 59–79. [Google Scholar]
- Hapke, H. Einfluss des tränkwassers auf die tiergesundheit: Toxikologisch bedingte risiken. Dtsch. Tierarztl. Wochenschr. 2000, 107, 355–356. [Google Scholar]
- Aslam, B.; Wang, W.; Arshad, M.I.; Khurshid, M.; Muzammil, S.; Rasool, M.H.; Nisar, M.A.; Alvi, R.F.; Aslam, M.A.; Qamar, M.U.; et al. Antibiotic resistance: A rundown of a global crisis. Infect. Drug Resist. 2018, 11, 1645–1658. [Google Scholar] [CrossRef] [PubMed]
- Bartley, P.S.; Domitrovic, T.N.; Moretto, V.T.; Santos, C.S.; Ponce-Terashima, R.; Reis, M.G.; Barbosa, L.M.; Blanton, R.E.; Bonomo, R.A.; Perez, F. Antibiotic Resistance in Enterobacteriaceae from Surface Waters in Urban Brazil Highlights the Risks of Poor Sanitation. Am. J. Trop. Med. Hyg. 2019, 100, 1369–1377. [Google Scholar] [CrossRef]
- CDC. Antibiotic Resistance Threats in the United States; CDC: Atlanta, Georgia, 2019. [Google Scholar]
- Solórzano-Santos, F.; Miranda-Novales, M.G. Essential oils from aromatic herbs as antimicrobial agents. Curr. Opin. Biotechnol. 2012, 23, 136–141. [Google Scholar] [CrossRef]
- Fotsing Yannick Stephane, F.; Kezetas Jean Jules, B. Terpenoids as Important Bioactive Constituents of Essential Oils. In Essential Oils—Bioactive Compounds, New Perspectives and Applications; IntechOpen: Rijeka, Croatia, 2020. [Google Scholar]
- Kumar, A.; Premoli, M.; Aria, F.; Bonini, S.A.; Maccarinelli, G.; Gianoncelli, A.; Memo, M.; Mastinu, A. Cannabimimetic plants: Are they new cannabinoidergic modulators? Planta 2019, 249, 1681–1694. [Google Scholar] [CrossRef]
- Caprari, C.; Fantasma, F.; Divino, F.; Bucci, A.; Iorizzi, M.; Naclerio, G.; Ranalli, G.; Saviano, G. Chemical Profile, In Vitro Biological Activity and Comparison of Essential Oils from Fresh and Dried Flowers of Lavandula angustifolia L. Molecules 2021, 26, 5317. [Google Scholar] [CrossRef]
- Wang, R.; Wang, R.; Yang, B. Extraction of essential oils from five cinnamon leaves and identification of their volatile compound compositions. Innov. Food Sci. Emerg. Technol. 2009, 10, 289–292. [Google Scholar] [CrossRef]
- Li, Y.; Kong, D.; Wu, H. Analysis and evaluation of essential oil components of cinnamon barks using GC–MS and FTIR spectroscopy. Ind. Crops Prod. 2013, 41, 269–278. [Google Scholar] [CrossRef]
- Yap, P.S.X.; Krishnan, T.; Chan, K.-G.; Lim, S.H.E. Antibacterial Mode of Action of Cinnamomum verum Bark Essential Oil, Alone and in Combination with Piperacillin, Against a Multi-Drug-Resistant Escherichia coli Strain. J. Microbiol. Biotechnol. 2015, 25, 1299–1306. [Google Scholar] [CrossRef]
- Satyal, P.; Murray, B.; McFeeters, R.; Setzer, W. Essential Oil Characterization of Thymus vulgaris from Various Geographical Locations. Foods 2016, 5, 70. [Google Scholar] [CrossRef] [PubMed]
- Galovičová, L.; Borotová, P.; Valková, V.; Vukovic, N.L.; Vukic, M.; Štefániková, J.; Ďúranová, H.; Kowalczewski, P.Ł.; Čmiková, N.; Kačániová, M. Thymus vulgaris Essential Oil and Its Biological Activity. Plants 2021, 10, 1959. [Google Scholar] [CrossRef] [PubMed]
- Borugă, O.; Jianu, C.; Mişcă, C.; Goleţ, I.; Gruia, A.T.; Horhat, F.G. Thymus vulgaris essential oil: Chemical composition and antimicrobial activity. J. Med. Life 2014, 7, 56–60. [Google Scholar]
- ISO ISO 4730:2017; Essential oil of Melaleuca, Terpinen-4-ol Type (Tea Tree oil). ISO: Geneva, Switzerland, 2017.
- Carson, C.F.; Hammer, K.A.; Riley, T. V Melaleuca alternifolia (Tea Tree) oil: A review of antimicrobial and other medicinal properties. Clin. Microbiol. Rev. 2006, 19, 50–62. [Google Scholar] [CrossRef]
- Lewis, J.S., II. M100 Performance Standards for Antimicrobial Susceptibility Testing; CLSI Clinical and Laboratory Standards Institute: Wayne, PA, USA, 2022; ISBN 978-1-68440-135-2. [Google Scholar]
- Mazzarrino, G.; Paparella, A.; Chaves-López, C.; Faberi, A.; Sergi, M.; Sigismondi, C.; Compagnone, D.; Serio, A. Salmonella enterica and Listeria monocytogenes inactivation dynamics after treatment with selected essential oils. Food Control 2015, 50, 794–803. [Google Scholar] [CrossRef]
- Yang, S.-K.; Low, L.-Y.; Yap, P.S.-X.; Yusoff, K.; Mai, C.-W.; Lai, K.-S.; Lim, S.-H.E. Plant-Derived Antimicrobials: Insights into Mitigation of Antimicrobial Resistance. Rec. Nat. Prod. 2018, 12, 295–396. [Google Scholar] [CrossRef]
- Derose, K.L.; Roche, L.M.; Lile, D.F.; Eastburn, D.J.; Tate, K.W. Microbial Water Quality Conditions Associated with Livestock Grazing, Recreation, and Rural Residences in Mixed-Use Landscapes. Sustainability 2020, 12, 5207. [Google Scholar] [CrossRef]
- Ballash, G.A.; Munoz-Vargas, L.; Albers, A.; Dennis, P.M.; LeJeune, J.T.; Mollenkopf, D.F.; Wittum, T.E. Temporal Trends in Antimicrobial Resistance of Fecal Escherichia coli from Deer. Ecohealth 2021, 18, 288–296. [Google Scholar] [CrossRef]
- Elmonir, W.; Abo Remela, E.M.; Alwakil, Y. Diversity, virulence and antibiogram traits of Escherichia coli recovered from potable water sources in Gharbia, Egypt. J. Water Health 2020, 18, 430–438. [Google Scholar] [CrossRef] [PubMed]
- Manyi-Loh, C.; Mamphweli, S.; Meyer, E.; Okoh, A. Antibiotic Use in Agriculture and Its Consequential Resistance in Environmental Sources: Potential Public Health Implications. Molecules 2018, 23, 795. [Google Scholar] [CrossRef]
- Arbab, S.; Ullah, H.; Wei, X.; Wang, W.; Ahmad, S.U.; Zhang, J. Drug resistance and susceptibility testing of Gram negative bacterial isolates from healthy cattle with different β—Lactam resistance Phenotypes from Shandong province China. Braz. J. Biol. 2023, 83, e247061. [Google Scholar] [CrossRef] [PubMed]
- Brochot, A.; Guilbot, A.; Haddioui, L.; Roques, C. Antibacterial, antifungal, and antiviral effects of three essential oil blends. Microbiologyopen 2017, 6, e00459. [Google Scholar] [CrossRef] [PubMed]
- Wińska, K.; Mączka, W.; Łyczko, J.; Grabarczyk, M.; Czubaszek, A.; Szumny, A. Essential Oils as Antimicrobial Agents—Myth or Real Alternative? Molecules 2019, 24, 2130. [Google Scholar] [CrossRef]
- Owen, L.; Laird, K. Synchronous application of antibiotics and essential oils: Dual mechanisms of action as a potential solution to antibiotic resistance. Crit. Rev. Microbiol. 2018, 44, 414–435. [Google Scholar] [CrossRef]
- Whiley, H.; Gaskin, S.; Schroder, T.; Ross, K. Antifungal properties of essential oils for improvement of indoor air quality: A review. Rev. Environ. Health 2018, 33, 63–76. [Google Scholar] [CrossRef]
- Shaaban, H.A. Essential Oil as Antimicrobial Agents: Efficacy, Stability, and Safety Issues for Food Application. In Essential Oils—Bioactive Compounds, New Perspectives and Applications; IntechOpen: Rijeka, Croatia, 2020. [Google Scholar]
- Blumenthal, K.G.; Peter, J.G.; Trubiano, J.A.; Phillips, E.J. Antibiotic allergy. Lancet 2019, 393, 183–198. [Google Scholar] [CrossRef] [PubMed]
- Swamy, M.K.; Akhtar, M.S.; Sinniah, U.R. Antimicrobial Properties of Plant Essential Oils against Human Pathogens and Their Mode of Action: An Updated Review. Evid.-Based Complement. Altern. Med. 2016, 2016, 3012462. [Google Scholar] [CrossRef]
- Yu, Z.; Tang, J.; Khare, T.; Kumar, V. The alarming antimicrobial resistance in ESKAPEE pathogens: Can essential oils come to the rescue? Fitoterapia 2020, 140, 104433. [Google Scholar] [CrossRef] [PubMed]
- Yap, P.S.X.; Yiap, B.C.; Ping, H.C.; Lim, S.H.E. Essential Oils, A New Horizon in Combating Bacterial Antibiotic Resistance. Open Microbiol. J. 2014, 8, 6–14. [Google Scholar] [CrossRef]
- Higgins, S.F.; Moser, L.; Laurent, K. Providing Water for Beef Cattle in Rotational Grazing Systems; University of Kentucky Libraries: Lexington, KY, USA, 2016. [Google Scholar]
- Kováts, E. Gas Chromatographic Characterization of Organic Substances in the Retention Index System; Giddings, J.C., Keller, R.A., Eds.; Marcel Dekker, Inc.: New York, NY, USA, 1965; Volume I, pp. 229–247. [Google Scholar]
- van den Dool, H.; Kratz, P.D. A generalization of the retention index system including linear temperature programmed gas-liquid par-tition chromatography. J. Chromatogr. A 1963, 11, 463–471. [Google Scholar] [CrossRef]
- NIST/EPA/NIH Mass Spectral Library. 2005. Available online: https://www.sisweb.com/manuals/nist05manual.pdf (accessed on 11 October 2022).
- McLafferty, F.W. Wiley Registry of Mass Spectral Data, with NIST Spectral Data CD Rom, 7th ed.; John Wiley & Sons: New York, NY, USA, 1998. [Google Scholar]
- Grob, R.L.; Kaiser, M.A. Qualitative and Quantitative Analysis by Gas Chromatography; Grob, B., Ed.; John Wiley & Sons: New York, NY, USA, 2004; ISBN 0-471-22983-0. [Google Scholar]
- ISO 19458:2006; Water Quality—Sampling for Microbiological Analysis. ISO Publishing: Geneve, Switzerland, 2006.
- ISO 9308-1:2014; Water Quality—Enumeration of Escherichia Coli and Coliform Bacteria—Part 1: Membrane Filtration Method for Waters with Low Bacterial Background Flora. ISO Publishing: Geneve, Switzerland, 2014.
- ISO 6222:1999; Water Quality—Enumeration of Culturable Micro-Organisms—Colony Count by Inoculation in a Nutrient Agar Culture Medium. ISO Publishing: Geneve, Switzerland, 1999.
- Balouiri, M.; Sadiki, M.; Ibnsouda, S.K. Methods for in vitro evaluating antimicrobial activity: A review. J. Pharm. Anal. 2016, 6, 71–79. [Google Scholar] [CrossRef] [PubMed]

| N. | Compound | Area % ± SD | |||
|---|---|---|---|---|---|
| EOs | Cinnamon | Thyme | Tea tree | Lavender | |
| 1 | Limonene | 1.35 ± 0.02 | 22.12 ± 1.53 | 2.25 ± 0.35 | |
| 2 | Cinnamaldehyde <(E)> | 77.14 ± 0.30 | |||
| 3 | Eugenol | 18.76 ± 0.23 | |||
| 4 | Methoxy cinnamaldehyde <(E)-o-> | 1.36 ± 0.04 | |||
| 5 | Pinene <α-> | 1.33 ± 0.02 | 11.52 ± 0.38 | ||
| 6 | Cymene <p-> | 21.83 ± 1.16 | 5.01 ± 0.23 | ||
| 7 | Linalool | 2.47 ± 0.02 | 36.0 ± 0.01 | ||
| 8 | Thymol | 38.05 ± 0.17 | |||
| 9 | Carvacrol | 8.70 ± 0.14 | |||
| 10 | Pinene <β-> | 4.24 ± 0.16 | |||
| 11 | Terpinene <α-> | 8.15± 0.22 | |||
| 12 | Cineole <1,8-> | 3.84 ± 0.31 | 9.00 ± 0.3 | ||
| 13 | Terpinene <γ-> | 16.52 ± 0.46 | |||
| 14 | Terpinolene | 2.50 ± 0.13 | |||
| 15 | Terpinen-4-ol | 32.52 ± 0.64 | 6.81 ± 0.02 | ||
| 16 | Terpineol <α-> | 4.98 ± 0.08 | |||
| 17 | Guaiene <α-> | 3.24 ± 0.05 | |||
| 18 | Valencene | 1.79 ± 0.01 | |||
| 19 | Camphor | 6.80 ± 0.07 | |||
| 20 | Borneol | 19.4 ± 0.1 | |||
| 21 | Linalyl acetate | 2.75 ± 0.02 | |||
| 22 | Farnesene <β-> | 1.50 ± 0.01 | |||
| Type | Name | Location Coordinate | Code |
|---|---|---|---|
| Water pool | Lago di Carpinone (IS) | 41.6100140 N 14.3753190 E | P1 |
| Water pool | Lago Castrati (IS) | 41.6153035 N 14.3991883 E | P2 |
| Water pool | Lago delle Cannavine (IS) | 41.6053227 N 14.4131814 E | P3 |
| Water pool | Lago di Acquaspruzza (IS) | 41.5947320 N 14.4044120 E | P4 |
| Stone trough | Sessano del Molise (IS) | 41.6337403 N 14.3301754 E | A1 |
| Stone trough | Carpinone (IS) | 41.5947320 N 14.4044120 E | A2 |
| Stone trough | Frosolone (IS) | 41.6137290 N 14.3975582 E | A3 |
| Stone trough | Frosolone (IS) | 41.6096087 N 14.3975582 E | A4 |
| Microbial Group | Water Pools | Stone Drinking Troughs | p |
|---|---|---|---|
| Log CFU/100 mL (±SD) | Log CFU/100 mL (±SD) | ||
| TMC 37 °C | 6.04 (0.44) | 4.97 (0.57) | <0.02 |
| TMC 22 °C | 5.11 (0.45) | 5.23 (0.68) | ns |
| Fungi & Yeast 22 °C | 4.11 (0.39) | 4.0 (0.66) | ns |
| Tot Colif 37 °C | 5.60 (1.26) | 2.92 (1.16) | <0.05 |
| Faecal Colif 44 °C | 2.85 (0.21) | 1.25 (0.73) | <0.05 |
| E. coli 44 °C | 3.40 (0.79) | 2.38 (0.91) | ns |
| Enterococci 37 °C | 3.04 (0.31) | 0.83 (0.55) | <0.01 |
| Salmonellae spp. 37 °C | absent | absent | ns |
| E. coli Isolates | REPEN [Benzylpenicillin 196.66 mg/mL + Dihydrostreptomycin 250 mg/mL] | MACRAMID [Lincomycin 50 mg/mL + Spectinomycin 100 mg/mL] | BAYTRIL [Enrofloxacin 100 mg/mL] | |||||||
|---|---|---|---|---|---|---|---|---|---|---|
| N.D. | 10−2 | 10−3 | 10−4 | N.D. | 10−3 | 10−4 | N.D. | 10−3 | 10−4 | |
| Activity | S | S | W | W | S | W | W | S | S | I |
| Mean | 32.6 | 18.2 | 11.2 | 2.0 | 36.1 | 7.5 | 0 | 47.2 | 20.3 | 16.0 |
| (±SD) | 4.01 | 5.25 | 6.37 | 5.17 | 4.99 | 5.03 | 0 | 4.08 | 4.81 | 7.39 |
| E. coli Isolates | AUGMENTIN [Amoxicillin 875 mg/mL + Clavulanic acid 125 mg/mL] | BIMIXIN [Neomycin Sulfate 33.11 mg/mL + Bacitracin 33.78 mg/mL] | ||||||
|---|---|---|---|---|---|---|---|---|
| N.D. | 10−2 | 10−3 | 10−4 | N.D. | 10−1 | 10−2 | 10−3 | |
| Activity | S | S | W | W | S | W | W | W |
| Mean | 40.8 | 20.3 | 12.7 | 1.10 | 19.6 | 11.3 | 4.2 | 0 |
| (±SD) | 2.92 | 12.19 | 9.04 | 4.03 | 4.09 | 2.35 | 3.48 | 0 |
| E. coli Isolates | Essential Oils | ||||||
|---|---|---|---|---|---|---|---|
| Thyme | Cinnamon | Tea Tree | Tween 20 | ||||
| 20 µL | 2 µL | 20 µL | 2 µL | 20 µL | 2 µL | 20 µL | |
| Activity | S | W | S | S | I | W | W |
| Mean (mm) | 36.3 | 12.9 | 30.3 | 22.2 | 15.4 | 0 | 0 |
| (±SD) | 0.98 | 0.46 | 0.64 | 0.38 | 0.41 | 0 | 0 |
| Statistical Significance EOs | Veterinary Medicine | Human Use | |||
|---|---|---|---|---|---|
| Repen 10−2 | Macramid 10−3 | Baytril 10−3 | Augmentin 10−2 | Bimixin 10−1 | |
| Thyme 20 µL | <0.01 | <0.01 | <0.01 | <0.01 | <0.01 |
| Cinnamon 20 µL | <0.01 | <0.01 | <0.01 | <0.01 | <0.01 |
| Tea tree 20 µL | ns | <0.01 | <0.01 | ns | <0.01 |
| Thyme 2 µL | <0.01 | <0.01 | <0.01 | ns | <0.05 |
| Cinnamon 2 µL | <0.05 | <0.01 | ns | ns | <0.01 |
| Tea tree 2 µL | <0.01 | <0.01 | <0.01 | <0.01 | <0.01 |
Publisher’s Note: MDPI stays neutral with regard to jurisdictional claims in published maps and institutional affiliations. |
© 2022 by the authors. Licensee MDPI, Basel, Switzerland. This article is an open access article distributed under the terms and conditions of the Creative Commons Attribution (CC BY) license (https://creativecommons.org/licenses/by/4.0/).
Share and Cite
Aquilano, C.; Baccari, L.; Caprari, C.; Divino, F.; Fantasma, F.; Saviano, G.; Ranalli, G. Effects of EOs vs. Antibiotics on E. coli Strains Isolated from Drinking Waters of Grazing Animals in the Upper Molise Region, Italy. Molecules 2022, 27, 8177. https://doi.org/10.3390/molecules27238177
Aquilano C, Baccari L, Caprari C, Divino F, Fantasma F, Saviano G, Ranalli G. Effects of EOs vs. Antibiotics on E. coli Strains Isolated from Drinking Waters of Grazing Animals in the Upper Molise Region, Italy. Molecules. 2022; 27(23):8177. https://doi.org/10.3390/molecules27238177
Chicago/Turabian StyleAquilano, Chiara, Ligia Baccari, Claudio Caprari, Fabio Divino, Francesca Fantasma, Gabriella Saviano, and Giancarlo Ranalli. 2022. "Effects of EOs vs. Antibiotics on E. coli Strains Isolated from Drinking Waters of Grazing Animals in the Upper Molise Region, Italy" Molecules 27, no. 23: 8177. https://doi.org/10.3390/molecules27238177
APA StyleAquilano, C., Baccari, L., Caprari, C., Divino, F., Fantasma, F., Saviano, G., & Ranalli, G. (2022). Effects of EOs vs. Antibiotics on E. coli Strains Isolated from Drinking Waters of Grazing Animals in the Upper Molise Region, Italy. Molecules, 27(23), 8177. https://doi.org/10.3390/molecules27238177

